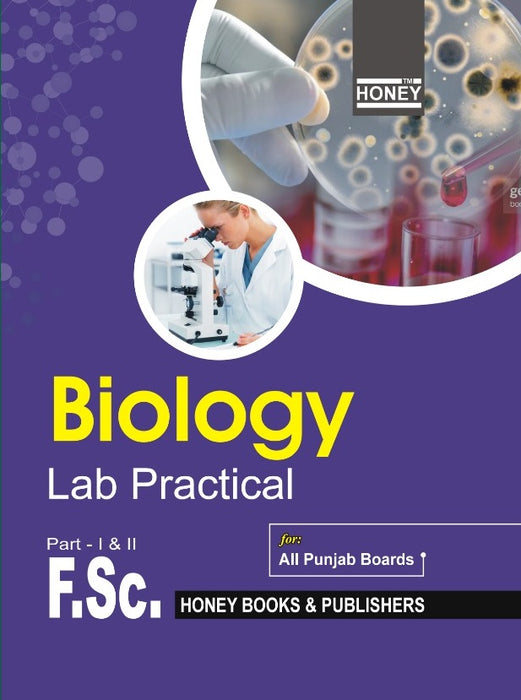

Honey Biology F.Sc ( Part I-II ) Practical Notebook
- Publisher: HONEY BOOKS AND PUBLISHERS
- Availability: In Stock
- SKU: 50285
Rs.550.00
Rs.650.00
Tags: - Experimental biology , best books , Best Selling Books , Biology education , Biology experiments , Biology investigations , Biology lab activities , Biology lab manual , Biology laboratory , Biology laboratory notebook , Biology practical demonstrations , Biology practical exercises , Biology practical guide , Biology practical notebook , Biology practical resources , Biology practical skills , Biology practicals , Biology projects , Biology research , Biology specimens , Experimental biology techniques , Experimental techniques , good books , High school biology , Laboratory experiments , Laboratory procedures , Scientific methods
This comprehensive practical notebook is tailored for students of F.Sc (Part I-II) focusing on honey biology. It is designed to provide an in-depth understanding of the theoretical concepts through hands-on experiments and observations. The notebook covers various topics related to honey production, bee anatomy, and the biochemical properties of honey, ensuring that students gain both practical skills and academic knowledge. By engaging in these meticulously crafted experiments, students will be able to appreciate the intricate processes involved in honey production and the role of bees in the ecosystem.
The practical notebook is structured to guide students step-by-step through each experiment, making complex concepts more accessible. Detailed instructions, clear illustrations, and well-defined objectives help students to follow along easily and perform experiments with confidence. Additionally, it includes sections for recording observations, analyzing data, and drawing conclusions, which are essential skills for any budding biologist. This methodical approach not only reinforces learning but also enhances critical thinking and scientific reasoning.
Furthermore, this notebook is aligned with the F.Sc curriculum, ensuring that all the key areas are covered comprehensively. It serves as an invaluable resource for both students and teachers, providing a solid foundation in honey biology. The practical activities are designed to complement classroom learning, making abstract concepts tangible and easier to grasp. Overall, this practical notebook is an indispensable tool for anyone aiming to excel in their F.Sc studies and develop a keen understanding of the biological sciences.
Keypoints:
- In-depth exploration of honey biology for F.Sc students.
- Hands-on experiments aligned with theoretical concepts.
- Step-by-step guidance through each experiment.
- Detailed instructions and clear illustrations.
- Sections for recording observations, analyzing data, and drawing conclusions.
- Enhances critical thinking and scientific reasoning skills.
- Complements classroom learning with practical applications.
- Aligned with the F.Sc curriculum for comprehensive coverage.
════ ⋆★⋆ ═══
Writer ✤ Test Prep Expert
Publishers ✤ HONEY BOOKS AND PUBLISHERS